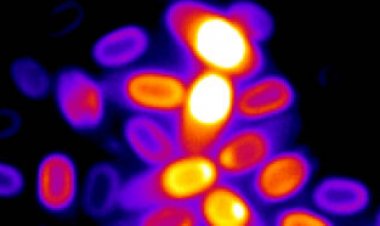
How dormant bacteria spores sense when it’s time to come back to life

The James Webb telescope revealed surprise asteroids in the Fomalhaut star system
New images of Fomalhaut confirm that an alleged planet is probably just dust while also revealing a new asteroid belt and a “Great Dust Cloud.”

The star Fomalhaut is ready for its close-up.
Rings of dust encircle the young star in stunning new images from the James Webb Space Telescope. The photos offer a clearer view of the star system — already famous for previous images of a purported, now widely disputed, planet. Features in the system include an oddly cockeyed asteroid belt, an expanding cloud of debris from a possible planet collision, and other unidentified bits that hint at a dynamic and crowded environment, researchers report May 8 in Nature Astronomy.
“It’s the first time we’re actually looking at the inner system, and it looks really different than I think anybody expected it to,” says astrophysicist Meredith MacGregor of the University of Colorado Boulder, who was not involved in the study. “The expectation was that there would be something like our solar system,” a place that is relatively mature and stable. “It really starts changing how we think about the dynamics of the [Fomalhaut] system.”
Fomalhaut, a scant 25 light-years away, is a young star at the center of a rapidly evolving planetary system. It was once thought to host one of the first planets to be photographed outside of our solar system (SN: 11/13/08). However, the existence of the planet — dubbed Dagon — has long been in question (SN: 1/26/12).
The new JWST images add to the growing evidence that Dagon is actually a cloud of dust. A collision among planets probably explains the dusty feature, says András Gáspár, an astronomer at the University of Arizona in Tucson. “It is fading, and it is expanding in size,” he says, as it follows a trajectory consistent with dust blowing in the stellar wind from Fomalhaut. Those are all characteristics more indicative of dust clouds than planets.
But just because Dagon hasn’t seemed to have panned out, that doesn’t mean there aren’t other planets lurking around Fomalhaut.
Indirect evidence for other worlds comes from an unexpected asteroid belt, seen for the first time in the new images. The belt is tilted at a jaunty 23 degrees from everything else seen in orbit around the star.
“This is a truly unique aspect of the system,” Gáspár says. The tilted belt, he says, could be the result of as-yet-undiscovered planets stirring up the debris around Fomalhaut.
MacGregor agrees. “If you see a disk that’s like this, that has an [elongated] outer ring and a bunch of dust that’s getting dragged in, there are probably planets there,” she says. “I think the easiest explanation [for the tilted belt] is there’s a planet in there, and the planet is on an orbit that is not aligned with the disk.” The misaligned planet, in turn, is dragging the asteroid belt off-kilter with respect to the plane of the solar system, she says.
The JWST images also turned up a newly identified feature in the outer belt around the star. It’s a blob that Gáspár and his colleagues call the Great Dust Cloud. It’s not yet clear whether it’s a real feature, or just some bright object shining through from beyond the Fomalhaut system.
“It could easily be a background galaxy,” Gáspár says, “which would be a really cruel trick by nature.” Follow-up observations with JWST will help them decide, he says. If the object stays put while the Fomalhaut system keeps spinning, then it’s a cosmic photobomber, lurking in the background.
The latest images answer some questions about Fomalhaut while raising a host of new ones, Gáspár says. “This single observation of Fomalhaut revealed way too many aspects of the system that we need to understand and unpack,” he says. “We set out to spatially resolve the asteroid belt component but ended up opening a much greater box of surprises.”
What's Your Reaction?